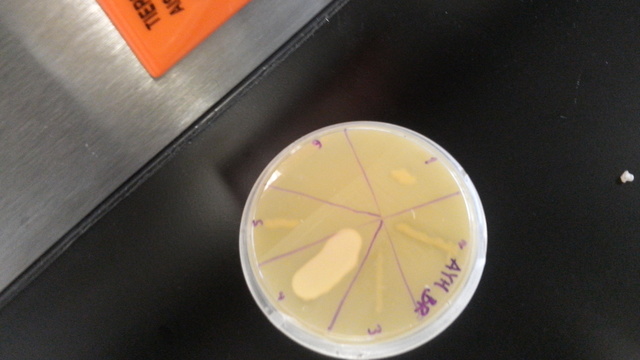
Semana i

-
Mi nacimineto.
-
Una de las actividades favoritas cuando era una niña
-
El basquetbol fue el primer deporte que jugue y que me formó como persona y me enseñó a trabajar en equipo.
-
El deporte que más me gusta jugar y uno de los trofeos que ganamos
-
Uno de los logros más importantes de mi vida fue la graduación de mi secundaria.
-
El ingreso al tec sede Durango, una decisión dificil
-
El primer trofeo que gane en el soccer como capitana del equipo
-
Una de las decisiones más dificiles pero la mejor
-
Momentos inolvidables en la carrera
-
Una semana llena de ratos, pero al final se logró con el propósto, aislar microorganismos degradadores de aciete.
-
Espero con ansias este día :)
-
Para esta fecha espero terminar una maestría.
-
Espero tener un trabajo fijo
-
Espero tener una empresa con mi hermano.
-
Una decisión importante.
Want to make a timeline like this?
Use Timetoast to turn dates, events, milestones, and phases into a clear visual timeline you can build and share. Timetoast is a timeline maker for work, school, research, and stories.